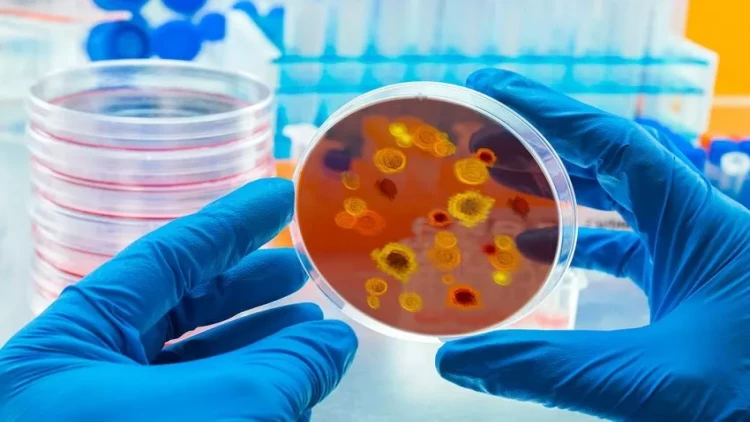
Davosda “COVID-19”dan 20 dəfə çox ölümə səbəb ola bilən “X xəstəliyi” müzakirə ediləcək

Davosda “COVID-19”dan 20 dəfə çox ölümə səbəb ola bilən “X xəstəliyi” müzakirə ediləcək
"X xəstəliyi" 2024-cü il yanvarın 15-dən 19-dək İsveçrənin Davos şəhərində keçiriləcək Dünya İqtisadi Forumunun mövzularından biri olacaq.
meqale.com report.az-a istinadən xəbər verir ki, bu barədə təşkilatın saytında məlumat verilib.
Görüş barədə yerləşdirilən elan da deyilir:
"Ümumdünya Səhiyyə Təşkilatının naməlum "X xəstəliyi"nin koronavirus pandemiyasından 20 dəfə daha çox ölümə səbəb ola biləcəyinə dair yeni xəbərdarlıqları ilə səhiyyə sistemlərini qarşıda duran çoxsaylı çağırışlara hazırlamaq üçün hansı yeni səylərə ehtiyac var?".
Müzakirə yanvarın 17-də baş tutacaq. Bu görüşün iştirakçıları Ümumdünya Səhiyyə Təşkilatının (ÜST) baş direktoru Tedros Adhanom Qebreyesus, Braziliyanın səhiyyə naziri Nisia Trindade Lima, koronavirus əleyhinə peyvənd hazırlayan "AstraZeneca" şirkətinin rəsmiləri və digər səhiyyə ekspertləri olacaq.

































